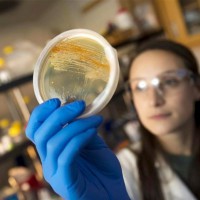

غيّب الموت عن 78 عاماً المهندس المعماري المتحدر من أوروغواي والمقيم في نيويورك رافاييل فينولي، الذي تولّى تصميم ناطحات سحاب حديثة شهيرة، أبرزها برج «ووكي توكي» في لندن، على ما أعلنت عائلته الجمعة الماضي.
وكتب ابنه رومان عبر الموقع الإلكتروني الخاص بالشركة التي أسسها فينولي وتتخذ من نيويورك مقراً «باسم عائلتي وزملائي وعدد كبير من شركائنا في العالم، أعلن ببالغ الأسى وفاة والدي بصورة مفاجئة الخميس في الثاني من مارس عن عمر ناهز الـ78 عاماً.
وتولّى المهندس المعماري الشهير، الذي كانت بعض أعماله تثير الجدل، تصميم أكثر من 600 مبنى في مختلف أنحاء العالم، منها فنادق وقاعات وملاعب ومطارات.
وفينولي مولود في عاصمة أوروغواي مونتيفيديو عام 1944 وفق تقرير وكالة الصحافة الفرنسية. وأشاد نادي مانشستر سيتي الإنجليزي لكرة القدم، الذي صمم فينولي أكاديميته «سيتي فوتبول أكاديمي»، بالمهندس المعماري في تغريدة عبر.
إلا أنّ بعضاً من مشاريع فينولي كانت تثير الجدل، كمبنى سكني فاخر في مانهاتن يبلغ ارتفاعه 426 متراً ومؤلف من 85 طابقاً، إذ يلاحق سكانه فينولي قضائياً بسبب الضجيج والاهتزاز الذي يُسجَّل داخل الشقق. وفي لندن، تناولت وسائل الإعلام ناطحة السحاب «ووكي توكي» عام 2013 لأنّ انعكاس أشعة الشمس على واجهتها الزجاجية، ألحق أضراراً بسيارة من نوع «جاغوار» كانت متوقفة في الأسفل. وقال ابنه إنّ «رافاييل فينولي ترك إرثاً غنياً من التصاميم المميزة جُسّدت في مبانٍ من بين الأشهر في العالم»، مشيراً إلى مركز منتدى طوكيو الدولي ومتحف كليفلاند للفنون.وكالات
دواء للسكري يُقلل مخاطر أمراض الكلى والجهاز التنفسي
اكتشف فريق بحثي في قسم الصيدلة بكلية الطب بجامعة هونغ كونغ، أن دواءً جديداً يستخدم لخفض الغلوكوز لمرضى السكري من النوع الثاني، يمكن أن يكون مفيداً في تقليل خطر إصابتهم بأمراض الكلى والجهاز التنفسي، بما في ذلك أمراض الكلى في مرحلتها النهائية، ومرض انسداد مجرى الهواء، والالتهاب الرئوي.
وخلال الدراسة المنشورة في العدد الأخير من دورية «علم الغدد الصماء والتمثيل الغذائي»، قدم الفريق البحثي دليلاً بالتجارب السريرية على أن مثبطات الناقل (SGLT2i)، وهي فئة جديدة من أدوية خفض الغلوكوز لمرض السكري من النوع 2. توفر إلى جانب التحكم في نسبة السكر بالدم، حماية من أمراض الكلى والالتهاب الرئوي.
وشملت التجارب السريرية بالدراسة، 30 ألف مريض يعانون من مرض السكري من النوع الثاني في هونغ كونغ، ووجد الفريق أنه بالمقارنة مع مثبطات (DPP4i) التقليدية التي يستخدمها المرضى، فإن المثبطات الجديدة (SGLT2i)، كانت مرتبطة بشكل كبير بانخفاض خطر الإصابة بأمراض الكلى بمراحله الأخيرة بنسبة 81 في المائة، وانخفاض خطر الإصابة بالفشل الكلوي الحاد بنسبة 70 في المائة، وانخفاض خطر الإصابة بـ«بيلة الألبومين» بنسبة 50 في المائة، فضلاً عن انخفاض أبطأ في معدل «الترشيح الكبيبي المقدر»، وكلها أدلة واقعية تشير إلى أن المثبطات الجديدة يمكن أن تمنح تأثيرات وقائية كلوية إضافية.
وبالنسبة لنتائج الجهاز التنفسي، ارتبطت مثبطات (SGLT2i) الجديدة، بشكل كبير بانخفاض خطر الإصابة بمرض انسداد مجرى الهواء بنسبة 35 في المائة، وانخفاض معدل تفاقم المرض بنسبة 46 في المائة، بالإضافة إلى انخفاض خطر الإصابة بالالتهاب الرئوي بنسبة 41 في المائة. ورغم ما أثبتته الدراسة القائمة على الملاحظة، يؤكد تشيونغ تشينغ لونغ، الأستاذ المساعد، في قسم الصيدلة، أن هناك حاجة لدراسات إضافية لتأكيد النتائج.
ويقول في تقرير نشره الموقع الإلكتروني لجامعة هونغ كونغ: «يجب إجراء المزيد من التجارب السريرية المتخصصة والتحليلات المجمعة للدراسات من مجموعات سكانية ومجموعات فرعية مختلفة، للخروج بنتيجة مؤكدة بأن دواء (SGLT2i) يمكن أن يكون عقاراً بديلاً أفضل لـ(DPP4i)، ويمكن استخدامه دواءً لضبط نسبة السكر في الدم».وكالات
«رادار منزلي» للتنبؤ بمرض ألزهايمر وحوادث السقوط
طوّر باحثون في جامعة تشالمرز للتكنولوجيا في السويد، طريقة للتنبؤ بحوادث السقوط والأمراض المعرفية مثل مرض ألزهايمر، من خلال قراءة نمط مشي الشخص بمساعدة مستشعر رادار، يمكن توصيله بالأثاث والجدران والسقوف، سواء في المنزل أو في أماكن الرعاية الصحية، وتم الإعلان عن هذه الأداة الجديدة في العدد الأخير من دورية «سينسورز».
ويقول زوشي تسنغ، باحث في الكهرومغناطيسية الطبية الحيوية في جامعة تشالمرز للتكنولوجيا، والباحث الرئيسي بالدراسة في تقرير نشره الخميس الماضي الموقع الإلكتروني لجامعة تشالمرز: «طريقتنا دقيقة وسهلة الاستخدام، حيث يمكن أن تساعد موظفي الرعاية الصحية على إجراء تحليل مخاطر أكثر موثوقية وتخصيص تدخلات لتحقيق تأثير كبير في وقت مبكر».
وتتزايد حوادث السقوط والأمراض المعرفية مثل مرض ألزهايمر مع تقدم العمر، والتدابير الوقائية مفيدة ويمكن أن تقلل من المعاناة والتكاليف، والطريقة التي ابتكرها باحثو تشالمرز تستخدم مستشعر رادار صغيراً للحصول على قراءة عالية الدقة في الوقت الفعلي لنمط مشي الشخص، خصوصاً الوقت اللازم لاتخاذ خطوة، وهذا يفيد في التنبؤ بالأخطار.
ويقول تسنغ إن «الاختلاف في أوقات الخطوات هو المفتاح في التنبؤ، فعادة ما يكون لدى الشخص السليم مشية منتظمة، ولكن غالباً ما يكون لدى الشخص المعرض لخطر حوادث السقوط تباين كبير في أوقات الخطوات، وعلى سبيل المثال، قد تستغرق الخطوة الأولى ثانية، بينما الثانية قد تستغرق ثانيتين».
والمنتج الذي يحتوي على المستشعر ليس أكبر من مجرد إنذار ويمكن استخدامه في نظام الرعاية الصحية أو في المنزل أو في بيئات رعاية كبار السن من أجل تحديد المخاطر، ويمكن تنفيذ تدابير وقائية مثل العلاج الطبيعي أو التدريب المخصص أو تكييف الأثاث في المنزل من أجل منع حوادث السقوط، وبالتالي تجنب المعاناة والرعاية في المستشفى المكلفة، وبصرف النظر عن كون هذه الأداة سهلة الاستخدام، هناك ميزة أخرى لهذه الطريقة وهي أنها تجمع البيانات دون تصوير، وهذا يعني أنه يمكن استخدامها دون التعدي على خصوصية الأشخاص، دون الشعور بالمراقبة التي قد تقدمها وسيلة مثل الكاميرا.
ويضيف أنه «مع الأمراض المعرفية مثل مرض ألزهايمر، غالباً ما تكون الزيادة في تقلب وقت الخطوة من الأعراض المبكرة، ويعد هذا المرض، أحد أكثر أسباب الخرف شيوعاً في العالم، ومن الصعب اكتشافه في مرحلة مبكرة، ويمكن أن تكون الطريقة مفيدة كوسيلة مساعدة لإجراء التشخيص المبكر، وتسهم في التدابير الوقائية وتحسين نوعية الحياة».وكالات
نوع نادر من الطيور يعاود الظهور في مدغشقر
عاود طائر من نوع «دَسكي تيتراكا» يعيش في مدغشقر فقط، الظهور في الدولة الأفريقية بعد انقراضه لـ24 عاماً، مما أثار ارتياح الأوساط العلمية المعنية.
ورُصد طائران من هذا النوع الذي يتميّز بحلق أصفر، خلال مهمة كان يجريها علماء طيور في إحدى الغابات النائية شمال شرقي مدغشقر خلال .واستغرق الفريق 40 ساعة في السيارة ونصف يوم مشياً، حتى وصل أعضاؤه إلى الأماكن التي شوهد فيها هذا النوع النادر من الطيور للمرة الأخيرة عام 1999.
واكتشف المتخصصون في تلك المنطقة غابةً وضعها سيئ بعدما حُوّلت مساحة كبيرة منها إلى مزارع لإنتاج نبتة «الفانيليا»، مع أنها تشكل أحد المواقع المحمية. وبعد أيام عدة، رُصد الطائر وهو يتنقّل بين الشجيرات قرب نهر صخري، والتقط الفريق صورة له.
وقال جون ميترماير، وهو المسؤول عن برنامج الطيور المنقرضة في منظمة «أميركن بيرد كونسرفنسي» غير الحكومية وأحد أعضاء الفريق: «في حال كان طائر الـ(دَسكي تيتراكا) يفضّل المناطق القريبة من الأنهار، فذلك قد يشكّل تفسيراً لسبب اختفائه لفترة طويلة».
وتابع أن «مراقبة الطيور في الغابات المطيرة تتمثل في الاستماع إلى أصواتها، فنميل تالياً إلى تجنب قضاء وقت طويل بجانب الأنهار التي يصدر منها ضجيج».
وتمكّن فريق آخر من رصد طائر «دَسكي تيتراكا» ثانٍ كان يحلّق معظم الوقت بجانب نباتات كثيفة قرب أحد الأنهار، يُحتمل أنه كان يبحث عن حشرات وفرائس أخرى.
وقالت ليلي-أريسون رينيه دي رولان، وهي مديرة برنامج مدغشقر لدى منظمة «ذي بيريغرن فاند»: «بما أننا عثرنا على (دَسكي تيتراكا) وفهمنا بصورة أفضل الموائل التي تعيش فيها هذه الطيور، بتنا قادرين على البحث عن طيور (دَسكي تيتراكا) في مناطق مدغشقرية أخرى».
وتُعد طيور الـ«دَسكي تيتراكا» أحد الأنواع العشرة المنقرضة التي يبحث عنها المتخصصون بصورة كبيرة. وتتولى إدارة هذه اللائحة كل من «ري: وايلد» و«أميركن بيرد كونسرفنسي» و«بيرد لايف إنترناشونال»، وهذه الجهات الثلاث هي شريكة في المهمّة.
ونصف الطيور في مدغشقر؛ أي نحو 115 نوعاً، لا تعيش سوى في هذا البلد.
وأُدرج أكثر من 40 نوعاً من هذه الطيور ضمن الحيوانات المهددة بالانقراض في القائمة الحمراء للاتحاد الدولي لحفظ الطبيعة. وأما طيور الـ«دَسكي تيتراكا»، فلم تُدرج في القائمة بسبب نقص في البيانات المرتبطة بها.
وتتمثل أبرز العوامل التي تؤدي إلى خسارة التنوع البيولوجي في مدغشقر، بتدمير الغابات وتدهور موائل الحيوانات، بالإضافة إلى انتشار الأنواع الغازية والتغير المناخي والصيد الجائر.وكالات
دلالات تعرّض البشر لهجمات الحيوانات
الحيوانات المفترسة الضخمة لها تأثير بالغ على الأنظمة البيئية التي تعيش فيها، غير أن جهود الحفاظ على هذه الحيوانات تواجه تحديات كبيرة، لا سيما عندما يتعرض البشر لهجمات تلك الضواري.
ويرجع الباحثون أسباب الصراع بين الإنسان والحيوانات المفترسة إلى سيناريوهين مختلفين، أولهما زيادة تعداد البشر في بعض مناطق العالم، مما يضطر السكان إلى توسيع البقعة العمرانية على حساب المناطق البرية التي تعيش فيها هذه الحيوانات، وثانيها، زيادة أعداد البشر والحيوانات بشكل متوازٍ في منطقة ما، لا سيما في المناطق التي هربت منها هذه الحيوانات في مراحل سابقة قبل أن تعود إليها مجدداً وتبدأ في التكاثر فيها بحيث ترتفع أعدادها من جديد.
وأجرى فريق بحثي مشترك تحت إشراف جوليا بومبيري من متحف «ميوز» للعلوم في إيطاليا دراسة تتناول الهجمات التي قامت بها الحيوانات المفترسة على البشر خلال الفترة ما بين 1950 حتى 2019. وسجل 5440 هجوماً قامت بها حيوانات من فصائل الكلبيات والسنوريات والدبيات علاوة على 12 فصيلة أخرى في أنحاء العالم.
وأشارت الدراسة، التي أوردتها الدورية العلمية «بلوس»، إلى أن البشر عدلوا طبيعة استغلال مساحات من الأراضي تتراوح ما بين 50 في المائة و70 في المائة من كوكب الأرض.
وأوضح الباحثون أن الهجمات التي سُجلت خلال فترة الدراسة كانت في تزايد، وأن أغلبها وقعت في الدول ذات الدخل المنخفض. وذكروا أن 68 في المائة من هذه الهجمات تسببت في إصابات للبشر وأن 32 في المائة منها كانت مميتة. وأضافوا أنه رغم أن هذه الهجمات تتنوع باختلاف فصيلة الحيوان والمناطق الجغرافية، فقد وجدوا أنها يمكن تصنيفها أيضاً في إطار اجتماعي واقتصادي، بمعنى أن البشر في الدول الفقيرة يتعرضون لمثل هذه الهجمات أثناء القيام بأنشطة تتعلق بالعمل، في حين أن سكان الدول الغنية يتعرضون لها أثناء القيام بأنشطة ترفيهية.
وعمد الباحثون إلى تجميع المادة العلمية الخاصة بالدراسة من الدوريات العلمية ورسائل الدراسات العليا والتقارير الإخبارية والمواقع الإلكترونية ومحركات البحث المختلفة. وتوصلوا إلى وجود سبعة سيناريوهات مختلفة وراء هجمات الحيوانات المفترسة على البشر، وهي كالتالي: ردود الفعل الدفاعية من الحيوانات، مثل شعور الأم بتعرض صغارها للخطر، والهجمات الناجمة عن المواجهات غير المتوقعة بين البشر والحيوان من مسافات قريبة، والهجمات المتعلقة بالغذاء، مثل الهجمات التي تقوم بها الحيوانات على البشر بغرض التهامهم أو دفاعاً عن الفريسة بعد اصطيادها، والهجمات الناجمة عن استفزازات البشر في حالة شعور الحيوان بالخطر، وهناك الهجمات لأغراض استكشافية مثل عندما يهاجم الحيوان البشر للتعرف ما إذا كان يصلح كفريسة محتملة، وأخيراً الهجمات التي تصدر دون استفزازات مسبقة.وكالات
العلماء يبحثون تحت الماء عن علاجات لأكثر من داء
ينكبّ علماء مستكشفون على البحث في قاع المحيطات عن جزيئات يمكن أن توفر في المستقبل علاجاً ثورياً للسرطان مثلاً أو مضادات حيوية جديدة شديدة الفاعلية، ويأملون في إيجاد ضالتهم في ميكروبات الرواسب وفي بكتيريا تتعايش مع حلزون البحر أو تتضمنها إفرازات الإسفنج.
وغالباً ما يضطر العلماء، بسبب ميزانياتهم المحدودة وعدم تلقيهم دعماً كافياً من المختبرات الكبرى، للانضمام إلى مجموعات أخرى من الباحثين وابتكار طرق للحصول على العينات اللازمة لأبحاثهم والتي قد تكون ببساطة أنبوباً من الوحل.
وعندما يجري التوصل إلى الفوائد التي ينطوي عليها أحد الجزيئات المُكتشفة في ما يخص الامراض كالزهايمر أو الصرع مثلاً، يستغرق تحويله إلى دواء أكثر من عقد، بتكلفة تبلغ مئات ملايين الدولارات.
وسُلّط الضوء على هذه الاكتشافات الرائدة والتي لا تزال محدودة، في إطار المفاوضات بين الدول الأعضاء في الأمم المتحدة والرامية إلى إبرام معاهدة لحماية أعالي البحار.
وتختلف الدول في شأن توزيع عائدات الموارد الجينية التي يتم جمعها في أعالي البحار، وتحديداً تلك المستخدمة في الأدوية أو البلاستيك الحيوي أو الإضافات الغذائية، على ما يوضح دانييل كاتشيلريس، وهو الرئيس المشارك في المباحثات من جانب تحالف “هاي سيز ألاينس” الذي يضم منظمات غير حكومية.
وليس مُتاحاً في الأسواق سوى عدد قليل من المنتجات المتأتية من موارد جينية بحرية، فيما جرى تسجيل سبعة منها فقط عام 2019، على قول كاتشيلريس.
وتراوح رسوم الحصول على تراخيص لتسويق منتجات مماثلة بين 10 و30 مليون دولار سنوياً. لكنّ التنوّع البيولوجي الهائل للمحيطات يشكل مؤشراً إلى وجود جزيئات كثيرة لم تُكتشف بعد.
يقول مارسيل غاسبارس من جامعة أبردين في اسكتلندا “كلّما بحثنا بصورة متزايدة، ارتفع احتمال التوصل إلى اكتشافات أكثر”.
ومنذ أن اكتشف ألكسندر فليمنغ عام 1928، نوعاً من العفن يقضي على البكتيريا هو البنسلين، عثر الباحثون على جزيئات علاجية في النباتات والحيوانات والحشرات والميكروبات… على اليابسة.
ويقول الأستاذ في معهد سكريبس لعلوم المحيطات في كاليفورنيا ويليام فينيكال إنّ “الغالبية الكبرى من المضادات الحيوية وأدوية السرطان متأتية من مصادر طبيعية”.
وعندما بدأ فينيكال (81 عاماً) الذي لا يزال يرأس أحد المختبرات، عمليات البحث عن الجزيئات البحرية عام 1973، سادت الشكوك في شأن إمكانية إنجاز الخطوة نفسها في البحار.
لكن في ثمانينات القرن العشرين، اكتشف وزملاءه نوعاً من المرجان الناعم في جزر الباهاما، ينتج جزيئاً له خصائص مضادات الالتهابات. واسترعى هذا الاكتشاف اهتمام شركة “استيه لودر” لمستحضرات التجميل التي استخدمته في منتجاتها.
إلا أنّ الكميات المطلوبة من المرجان لتسويق الجزيء دفعت فينيكال للتخلي عنه والتركيز على الكائنات الحية الدقيقة. وبات الباحثون حالياً يستخرجون الرواسب من قاع المحيطات ثم يربّون الميكروبات في المختبرات.
وفي جزر البهاماس أيضاً، اكتشف العلماء عام 1991، بكتيريا لم تكن معروفة هي سالينيسبورا، تدخل راهناً في تركيبة عقارين مضادين للسرطان، يخضعان حالياً لمراحل التجارب السريرية النهائية.
لم يحمل هذا المسار الطويل مفاجأة لكارمن كويفاس مارشانته، وهي رئيسة قسم الأبحاث في شركة “فارما مار”الإسبانية للتكنولوجيا الحيوية.
وخلال تطوير أول عقار لها، بدأت الشركة بجمع 300 طن من الكيسيات، وهو أحد أنواع اللافقاريات الأسطوانية التي يمكن إيجادها على الصخور أو تحت القوارب.
وتقول كويفاس مارشانتت “إنّ عزل أقل من غرام واحد من الجزيء، وهي خطوة ضرورية لإجراء الاختبارات، تطلّب طنّاً من الكيسيات. وتمكنت الشركة من ابتكار ثلاثة عقاقير مضادة للسرطان أُجيز استخدامها كلها، بالإضافة إلى تحسين طرق التصنيع الخاصة بها.
وفي المجموع، أُجيز استخدام 17 دواء متأت من جزيئات بحرية لعلاج الأمراض منذ عام 1969، فيما لا يزال 40 عقاراً في مراحل من التجارب السريرية في مختلف أنحاء العالم، على ما يذكر موقع “مارين درَغ بايبلاين”الإلكتروني.
وتعالج معظم هذه الأدوية مرض السرطان، فيما تشكل عقاقير أخرى مضادة لفيروس الهربس مُستخرجة من الاسفنجيات، بالإضافة إلى مسكن للآلام متأت من أحد أنواع الحلازين.
ويُرجع الخبراء أحد أسباب العدد المحدود للعقاقير إلى التكلفة الباهظة للتجارب التي تتجاوز أحياناً المليار دولار.
ويقول أليخاندرو ماير، وهو أستاذ متخصص في علم الادوية لدى جامعة ميدويسترن، إن ثمة “عدداً لا يحصى من الأبحاث المرتبطة بالامراض، بدءاً من الملاريا وصولاً إلى السل”.
وقد يكون الجزيء الذي سيتألف منه المضاد الحيوي المقبل أو العلاج المستقبلي ضد فيروس نقص المناعة البشرية، موجوداً داخل كائن يعيش في قاع البحار أو يتشبّث بهيكل قارب، أو قد يكون أصلاً في حوزتنا، داخل المكتبات الكبيرة للجزيئات التي لا يزال يتعيّن إخضاعها للاختبارات.وكالات
تُحول حمام قديم إلى تحفة فنية بـ 30 دولار فقط
نجحت امرأة بريطانية بتحويل حمامها القديم الذي يعود إلى الثلاثينيات من القرن الماضي، إلى حمام عصري وأنيق بميزانية محدودة للغاية.
قامت آلي باكلي، من مدينة هامبشير، بتحديث حمام منزلها بتكلفة لم تتجاوز 25 جنيهاً استرلينياً أي ما يعادل قرابة 30 دولاراً أمريكياً، باستخدام مكونات بسيطة شملت لفة من الفينيل سعرها 15 دولاراً، وطلاء أسود اللون بسعر 12 دولار.
وشاركت آلي النتائج التي حصلت عليها في مقطع فيديو على حسابها على تيك توك، وكتبت معلقة على الفيديو: “ هذا ما يجب فعله، عندما يكون لديك حمام قديم ممل وميزانية محدودة”
ومنذ نشره على تيك توك، حصل الفيديو على 870 ألف مشاهدة و 119 ألف إعجاب. وفي منشور آخر، شاركت آلي الخطوات التي اتبعتها لتحدث حمام منزلها، حيث قالت إنها غطت مقصورات المطبخ بالفينيل اللاصق، قبل أن تقوم بطلائه باللون الأسود.
كما أنها استخدمت غلافاً من الفينيل بتأثير خشبي فاتح وطلت الجدران بطلاء برتقالي ورمادي، وأضافت سلالاً وأواني نباتات حديثة لإضفاء المزيد من الجمالية على الحمام. استخدمت آلي أيضاً طلاءً أسود غير لامع، لطلاء البلاط الملون، وفق ما أورد موقع “ميترو” الإلكتروني.وكالات
التوقيع اللافت أحدث صيحات عمليات التجميل
في حين يسعى العديد من الأفراد إلى تجديد منازلهم لجعلها أكثر حداثة وأناقة، أو ربما إجراء عمليات لتجميل مظهرهم الخارجية، هناك فئة جديدة من الأشخاص باتوا يلجأون إلى إجراء عمليات لتجميل توقيعاتهم.
وبحسب تقرير وكالة “اسوشييتد برس”، تم رصد مجموعة من الأشخاص التي تعمد إلى توظيف أشخاص، وتحديداً خطاطين، من أجل التدريب على الكتابة والتخطيط باستخدام قلم أو ريشة أو أي وسيلة كتابة أخرى.
ويفيد التقرير أن هذه الموجة من الاهتمام تتزايد يومياً مع إمكانية العثور على شاغلي هذه المهنة أكثر وأكثر عبر تيك توك وانستغرام وغيرها من منصات التواصل.
بدأت هذه الصيحة في الصين، وتم إطلاق مصطلح “تصميم التوقيعات”، وهو تصميم مهني لتحسين شكل الاسم عند الكتابة. وأثار هذا الاتجاه اهتماماً واسعاً حول العالم، حتى وصل إلى الأطباء والمحامين والمشاهير.
يتميز تصميم التوقيعات بأنه يتيح للأفراد تحسين شكل كتابة أسمائهم، وإضفاء لمسة شخصية عليها، وبذلك يكونوا قادرين على تمييز أنفسهم في أي وثيقة رسمية أو توقيعاتهم على المستندات الشخصية. ويتم تصميم التوقيعات بالاستناد إلى الذوق الشخصي والأسلوب الفريد لكل شخص.
يشير المهتمون بتصميم التوقيعات إلى أنه يمكن للشخص أن يحدث فرقاً كبيراً في شكل توقيعه بمجرد تغيير طريقة كتابته، ويتطلب هذا التغيير مساعدة متخصصة في هذا المجال، والتي يمكن الحصول عليها بسهولة من خلال تطبيقات التواصل الاجتماعي والمواقع الإلكترونية المختصة.
تقوم بريسيليا مولينا من مدينة لوس أنجلوس الأمريكية بعمل ما لا يقل عن 300 توقيع شخصي مخصص في الشهر، مقدمة حزم تشمل حتى ثلاثة طرق للتوقيع، وحرية تعديل غير محدودة أو حتى تحديث مجموعة جديدة من الأحرف الأولى. تتراوح تكلفتها بين 10 إلى 55 دولاراً، باستخدام الشعار: “حيث تلتقي الأصالة والتراث”.
وقالت مولينا إن عملائها في Planet of Names يشملون المحترفين والشخصيات الشهيرة الذين يبحثون عن طرق جديدة للتوقيع، على الرغم من أنها لا تفصح عن هويات المشترين الشهيرين.
وترى مولينا أن الأفراد يأتون إليها وإلى مثيلاتها من المتخصصين في تصميم التوقيعات لسبب بسيط: التعب من الطريقة التي يوقعون بها أسمائهم.وكالات
القلق وعدم الارتياح علامة على وجود مشكلة في القلب
غالباً ما تصيب أمراض القلب كبار السن ومتوسطي العمر، وكذلك أولئك الذين يعانون من السمنة، ومع ذلك، قد تبدأ أعراض هذه الأمراض بشكل خفي في سن مبكرة.
فيما يلي مجموعة من الأعراض الغير اعتيادية التي تظهر في سن العشرينيات والثلاثينات من العمر والتي يمكن أن تكون مؤشراً على الإصابة بأمراض القلب في المستقبل، وفق ما أوردت صحيفة ديلي ميل البريطانية:
في بعض الحالات، قد يكون الشعور بالقلق وعدم الارتياح علامة على وجود مشكلة في القلب. وبحسب الخبراء، فإن القلق وأمراض القلب مرتبطان بشكل وثيق، إذ أن القلق المستمر يؤدي إلى الإجهاد الذي يؤدي بدوره إلى إتلاف القلب بمرور الوقت.
قد تظهر مشاكل في القلب مثل الخفقان أو عدم انتظام ضربات القلب، والتي تسبب التوتر والإجهاد. وأظهرت دراسة أجراها باحثون في جامعة هارفارد عام 2015 أن الأشخاص الذين يعانون من القلق كانوا أكثر عرضة للإصابة بمرض الشريان التاجي، وازدادت لديهم نسبة الوفاة بهذا المرض بنسبة 21٪.
يمكن أن يكون التنميل والألم والوخز في الساقين علامة على عدم وجود كمية كافية من الدم في أطراف الجسم. وتحدث هذه الحالة المعروفة باسم مرض الشرايين المحيطية (PAD)، عندما تصبح الشرايين في الساقين ضيقة نتيجة تراكم اللوحات الدموية.
يمكن أن يحدث هذا لعدة أسباب، مثل سوء النظم الغذائية الغنية بالصوديوم أو الكوليسترول، والإجهاد الشديد، والتدخين والسمنة.
توجد خمسة شرايين في ساقي الإنسان، يلعب كل منها دوراً حاسماً في توزيع الدم إلى أبعد مناطق الجسم ثم العودة إلى القلب. عندما تنسد أو تتضيق هذه الشرايين، يضعف تدفق الدم إلى المناطق السفلية من الجسم، وبالتالي يمكن أن تؤدي إلى الشعور بالوخز أو الألم في الساقين.
ويقول الخبراء، إن هذه العلامات قد تكون دليلاً على قرب الإصابة بنوبة قلبية أو سكتة دماغية، لذا يجب عدم تجاهلها واستشارة الطبيب على الفور عند الشعور بها.
غالباً ما يعاني الأشخاص الذين يعانون من أمراض القلب من آلام مفاجئة وقصيرة الأمد في المعدة في البداية. ومع تفاقم حالة القلب والأوعية الدموية، تحدث مشاكل الجهاز الهضمي بشكل أكثر تواتراً.
ويحدث عادة ألم مفاجئ وحاد، في الجزء الأيمن العلوي من المعدة، ويمكن أن يكون هذا بسبب ذبحة صدرية معوية، والتي تحدث عندما لا تصل كمية كافية من الدم إلى القولون.
قد يكون التعب الشديد علامة على وجود مشكلة في قلبك. وبحسب الخبراء، فإن التعب قد ينجم عن عدم مقدرة القلب على توزيع كمية كافية من الدم إلى الأعضاء الحيوية. وهذا يمكن أن يسبب مجموعة من القضايا، مثل فشل الرئتين في سحب كمية كافية من الأكسجين، وعندما لا تتلقى الكلى ما يكفي من الدم، ستواجه مشكلة في إزالة الفضلات من الجسم. كما يمكن أن يصاب الكبد بالفشل إذا لم يحصل على كمية كافية من الدم.
ويعتبر التعب الشديد من أولى علامات كل من هذه الأمراض، لذا ينصح الأطباء الأشخاص الذين يعانون من التعب المزمن بالحصول على العناية الطبية.
التعرق الغزير هو عرض غريب ولكنه شائع لمشاكل القلب. غالباً ما يتعرق الأشخاص الذين يعانون من أمراض القلب والأوعية الدموية نتيجة اضطرار أجسامهم إلى بذل جهد أكبر لضخ الدم.
يحافظ التعرق أيضاً على انخفاض درجة حرارة الجسم، مما يقلل من عبء عمل القلب، كما أنه يزيل السوائل الزائدة من الجسم، مما يقلل من عبء عمل الكلى في تنظيف سوائل الجسم.
ويحذر الأطباء من أن التعرق الغزير المفاجئ، خاصة عندما لا يكون ناجماً عن ممارسة النشاط البدني، قد يكون من أولى علامات الإصابة بنوبة قلبية.وكالات
“الأسباب متعددة العوامل” تضبط كيمياء الصداع النصفي
يصف روبرت كانيكي مدير مركز الصداع في جامعة بيتسبرغ “الأسباب متعددة العوامل” التي تحرّك نوبات الصداع النصفي بأنها قائمة من المشغلات الفردية التي تطلق هذا الصداع، وتحدد مدى شدته، وزمن استمراره.
وفي تقرير نشره موقع “إفري داي هيلث”، يوضح كانيكي “قد يسبب تخطي الوجبات نوبة صداع نصفي، لكن إذا عدت إلى المنزل في وقت متأخر من اجتماع عمل مرهق، وذهبت إلى الفراش من دون عشاء، قد تواجه نوبة أكثر شدة”.
ويتضمن التقرير 14 عاملاً مسبباً لنوبات الصداع النصفي، تعمل كل مجموعة منها كمشغل لنوبة صداع، وتحدد مدى شدة الألم، واستمراره والذي قد يمتد لعدة أيام.
والعوامل هي: الحصول على الكثير أو القليل من النوم. وعدم تناول الطعام لفترة طويلة. وزيادة أو انخفاض مستوى الإجهاد. وتناول القليل أو الكثير جداً من الكافيين. والجفاف. والإرهاق البدني.
وتشمل أيضاً: الدورة الشهرية. وشرب الكحول. وتناول بعض الأطعمة، مثل الجبن واللحوم المعالجة. والتدخين أو التعرض للدخان. والحر الشديد. والأضواء الساطعة. وآلام الرقبة. والتعرض لبعض الروائح.
وتنصح كليفلاند كلينك بمجموعة من العادات التي تقلل نوبات الصداع النصفي وتخفف شدتها، منها: تناول الوجبات والوجبات الخفيفة في جدول زمني منتظم، والنوم على جدول منتظم، وتجنب القيلولة في عطلات نهاية الأسبوع، والبقاء رطباً عن طريق شرب الكثير من الماء، والانتظام في النشاط البدني، وممارسة تقنيات الاسترخاء.وكالات